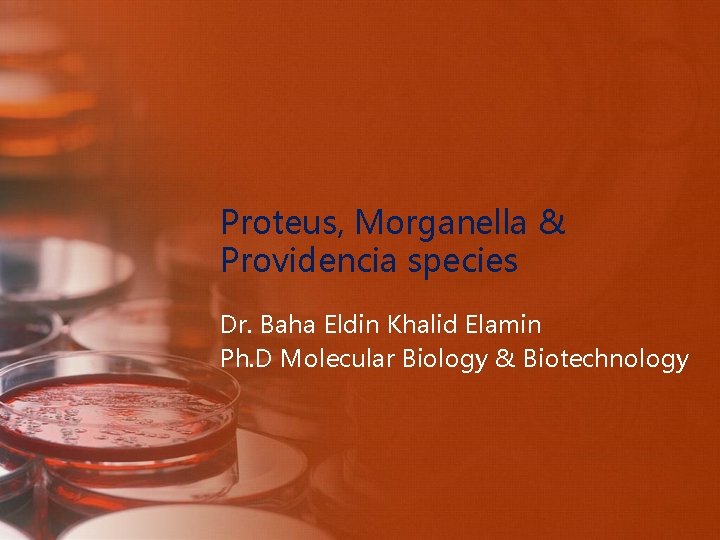
Proteus, Morganella & Providencia species Dr. Baha Eldin Khalid Elamin Ph. D Molecular Biology
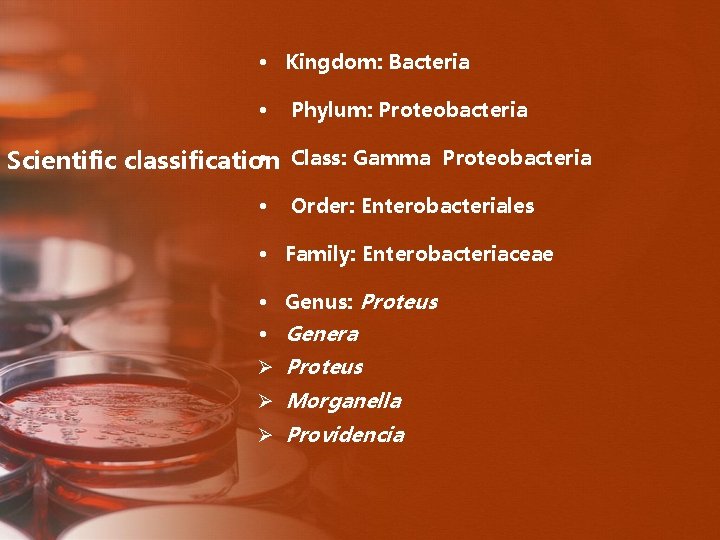
• Kingdom: Bacteria • Phylum: Proteobacteria • Class: Gamma Proteobacteria Scientific classification •
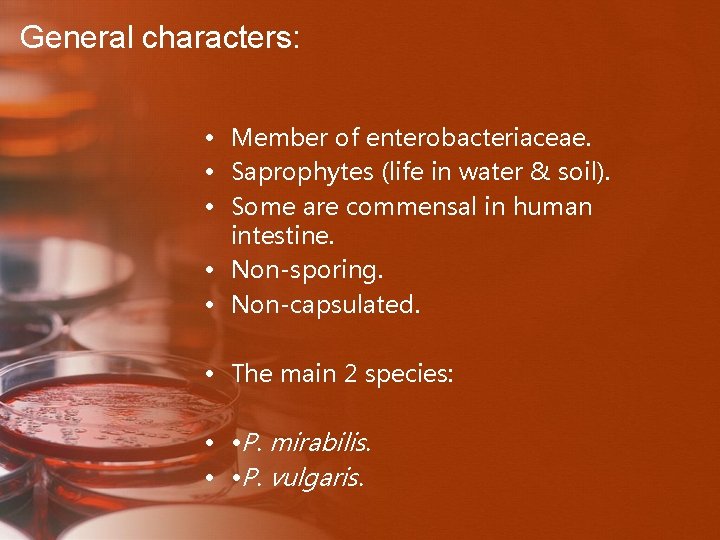
General characters: • Member of enterobacteriaceae. • Saprophytes (life in water & soil). •
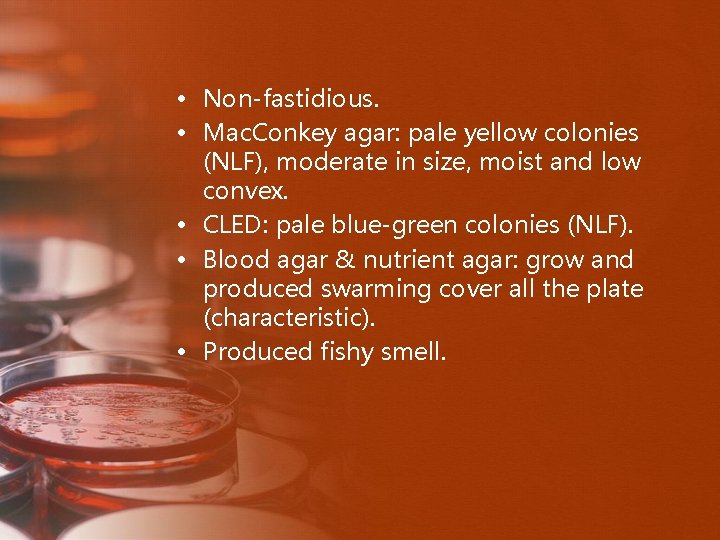
• Non-fastidious. • Mac. Conkey agar: pale yellow colonies (NLF), moderate in size,
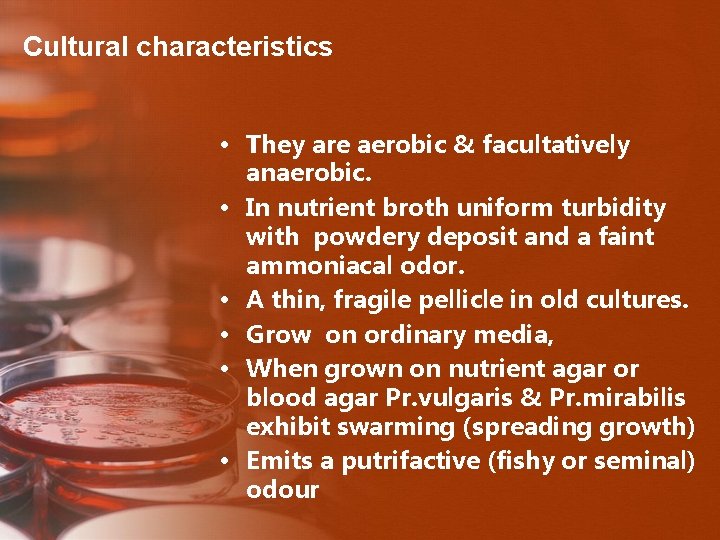
Cultural characteristics • They are aerobic & facultatively anaerobic. • In nutrient broth uniform
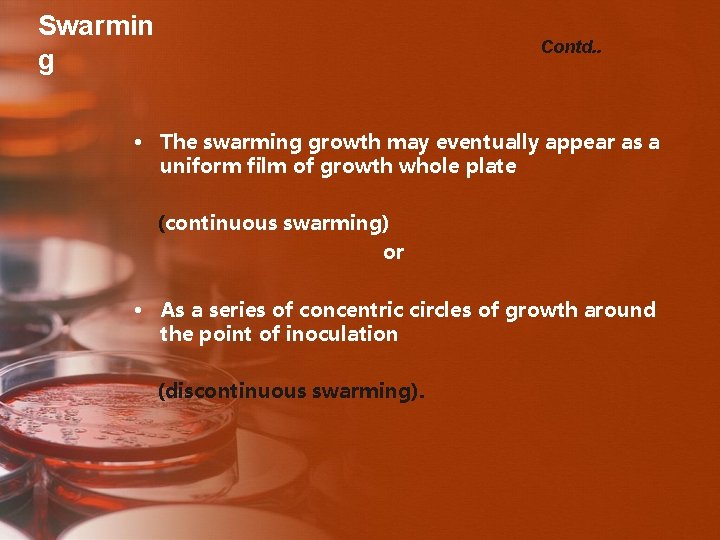
Swarmin g Contd. . • The swarming growth may eventually appear as a uniform
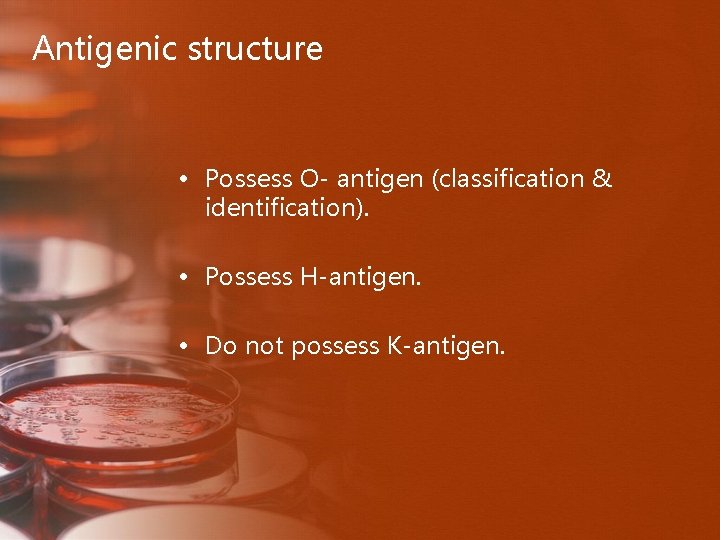
Antigenic structure • Possess O- antigen (classification & identification). • Possess H-antigen. • Do
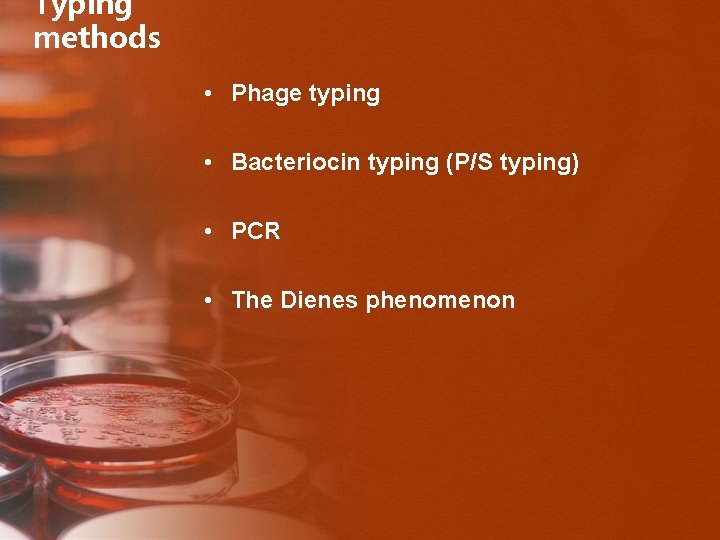
Typing methods • Phage typing • Bacteriocin typing (P/S typing) • PCR • The
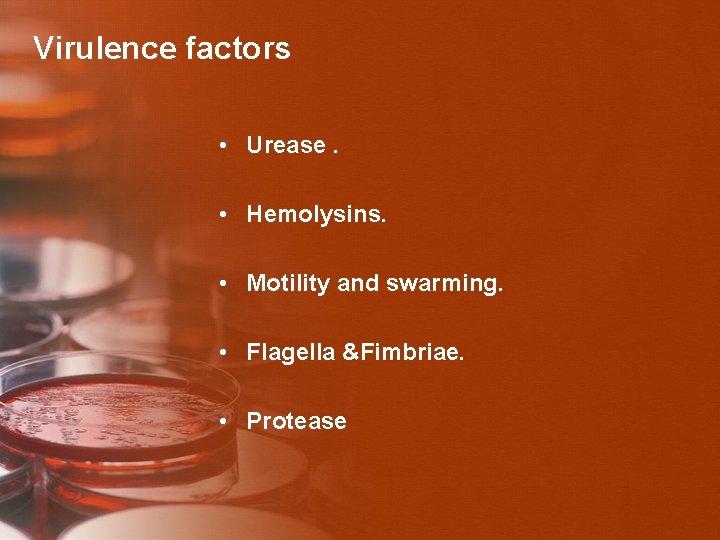
Virulence factors • Urease. • Hemolysins. • Motility and swarming. • Flagella &Fimbriae. •
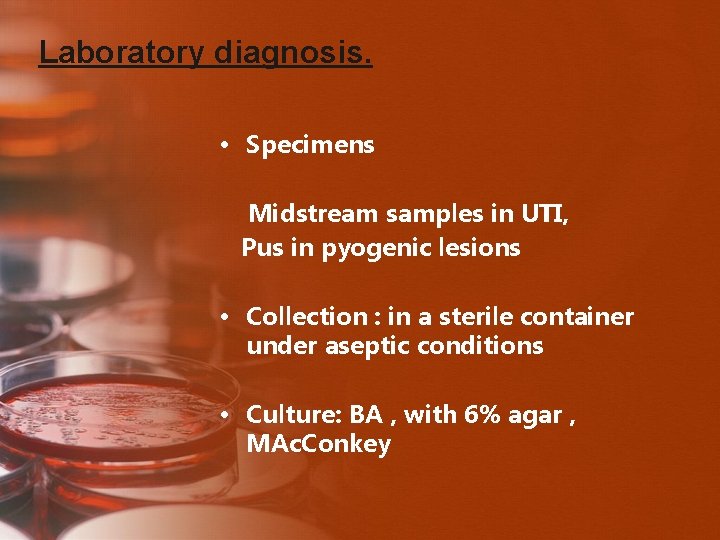
Laboratory diagnosis. • Specimens Midstream samples in UTI, Pus in pyogenic lesions • Collection
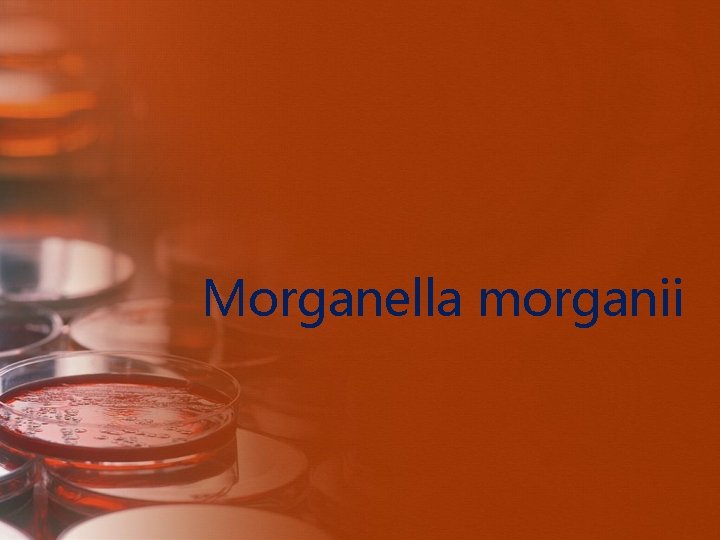
Morganella morganii
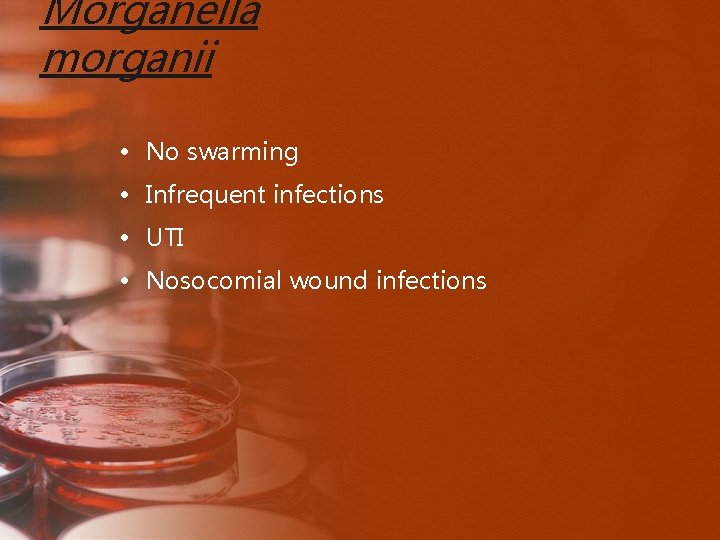
Morganella morganii • No swarming • Infrequent infections • UTI • Nosocomial wound infections

Proteus Morganella Providencia species Dr Baha Eldin Khalid
Proteus, Morganella & Providencia species Dr. Baha Eldin Khalid Elamin Ph. D Molecular Biology & Biotechnology

Enterobacteriaceae: Major Genera • • • Escherichia Shigella Salmonella Edwardsiella Citrobacter Yersinia Klebsiella Enterobacter Serratia Proteus Morganella Providencia

Proteus, Morganella & Providencia species • • All are normal intestinal flora Opportunistic pathogens Deaminate phenylalanine All are lactose negative

Proteus
• Kingdom: Bacteria • Phylum: Proteobacteria • Class: Gamma Proteobacteria Scientific classification • Order: Enterobacteriales • Family: Enterobacteriaceae • Genus: Proteus • Genera Ø Proteus Ø Morganella Ø Providencia

General Characteristics • • Pleomorphic (Greek god Proteus) Motile, Non-capsulated Urease +ve PPA test +ve Lactose not fermented MR (+) ; VP (-) Somatic O and flagellar H Ag Weil & Felix (1916) Ø Flagellated strains - Hauch form Ø Non flagellated - Ohne Hauch form

Proteus Species: • Proteus vulgaris. • Proteus mirabilis. • Proteus myxofaciens. • Proteus penneri. • Proteus hauseri. • Genomospecies 4, 5, and 6.

Proteus Con. • Morganella morganii. • Providencia alcalifaciens. • Providencia stuartii. • Providencia rettgerii (previously Proteus rettgeri).

Morphology

Morphology • Gram negative bacilli, (1– 3 X 0. 5μm) poleomorphic. • In young cultures, cells are long, curved, and filamentous, arranged concentrically. • In older cultures, no characteristic arrangement. • Non-capsulated, non-sporing & actively motile.

Morphology Contd. . • Possess peritrichate flagella & many strains posses fimbriae. • Flagella are more variable in shape • Normal and ‘curly’ forms.
General characters: • Member of enterobacteriaceae. • Saprophytes (life in water & soil). • Some are commensal in human intestine. • Non-sporing. • Non-capsulated. • The main 2 species: • • P. mirabilis. • • P. vulgaris.
• Non-fastidious. • Mac. Conkey agar: pale yellow colonies (NLF), moderate in size, moist and low convex. • CLED: pale blue-green colonies (NLF). • Blood agar & nutrient agar: grow and produced swarming cover all the plate (characteristic). • Produced fishy smell.
Cultural characteristics • They are aerobic & facultatively anaerobic. • In nutrient broth uniform turbidity with powdery deposit and a faint ammoniacal odor. • A thin, fragile pellicle in old cultures. • Grow on ordinary media, • When grown on nutrient agar or blood agar Pr. vulgaris & Pr. mirabilis exhibit swarming (spreading growth) • Emits a putrifactive (fishy or seminal) odour



Swarmin g • A group of cells at the edge of a developing microcolony migrate to an uninoculated area of the medium. • During an incubation period of about 2– 4 h at 37°C, bacterial cell, which is in the form of a vegetative cell, receives a number of signals. • The signals from the environment include, Ø Ø Ø its viscosity, temperature, the presence of a solid surface, and the composition and concentration of nutrients.

Swarmin g Contd. . • The signals from within and between the vegetative cells include Ø growth rate Ø population density Ø presence of particular peptides and amino acids Ø other key substances such as the quorum sensing autoinducer 2 (AI-2).
Swarmin g Contd. . • The swarming growth may eventually appear as a uniform film of growth whole plate (continuous swarming) or • As a series of concentric circles of growth around the point of inoculation (discontinuous swarming).




Anti-swarming agents • These include: 1. physically restricting the movement of Proteus cells by Ø means of agar overlays or poured plates. Ø or by increasing the agar concentration to 3– 4 % w/v.

Anti-swarming agents Contd. . 2. by affecting the flagella through the incorporation of Ø polyvalent H antisera. Ø ethanol 5. 5 percent. Ø boric acid 0. 1 percent, . Ø Detergents. Ø bile salts, or other surface-active agents. Ø or β-phenethyl alcohol.

Anti-swarming agents Contd. . 3. retarding the cell growth rate by incorporating growth inhibitors such as Ø Sulfonamide. Ø neomycin. Ø chloral hydrate. Ø Barbiturates. Ø sodium azide. Ø purine bases.

Anti-swarming agents Contd. . 4. Some anti-swarming methods act by mechanisms which are as yet unexplained. • eg: Activated charcoal inhibit swarming without affecting motility, but some components of media, notably blood, make the charcoal ineffective. • Swarming is inhibited in Mac. Conkey agar by the bile salts and Wilson and Blair’s medium by the bismuth sulfite. • Swarming rarely occurs in the absence of electrolytes. Useful alternative anti-swarming media are Lab- Lemco without added salt, and (CLED) agar

Anti-swarming agents Contd. . • Many of these agents are unsuitable for use • Some agents are toxic and prevent the growth of delicate pathogens. • One exceptional agent is p-nitrophenylglycerol , I. Inhibits the formation of swarm cells. II. Without affecting the formation or motility of flagella. III. Nontoxic for delicate bacterial pathogens such as Neisseria gonorrhoeae. IV. No effect on red blood cells & colonial morphology of other organisms and their antibiotic sensitivity
Antigenic structure • Possess O- antigen (classification & identification). • Possess H-antigen. • Do not possess K-antigen.

Culture on Mac. Conkey agar o colonies are smooth o beaten-copper surface o consist of regular bacillary forms which on other media give rise to discontinuous swarming o Flat, Rough & Larger colonies o consist of long filaments o continuous swarming on other media. o colonies are smaller, smoother & more conical; o pleomorphic cells o do not swarm on other media

Culture on Mac. Conkey agar

Dienes phenomenon • When different strains of Proteus spp. are allowed to swarm towards each other, A line of completely or partially inhibited growth forms where the spreading growths of incompatible strains meet. • Such a line does not form between identical strains. • It is known as Dienes phenomenon.

Biochemical reactions • All strains are • catalase-positive and oxidase negative. • Ferments glucose with small amounts of gas. • Lactose fermentation is rare. • Sucrose fermented by most strains except P. mirabilis (only 15– 20% are positive). • Unlike strains of Morganella and Providencia, no strain of Proteus forms acid from mannose, mannitol, adonitol, or inositol. • All species produce an inducible urease.

Sp. swarmin g gas ure ind orn H 2 S gel man ado n malt tre xyl P. mirabilis + + + - - - + + P. Penneri + +/- + - - +/- - - + +/- + P. vulgaris + + - - + +/- + M. morgan ii - + + +/- - + - - Prov. alcalifacie ns - + - - - + + - - - Prov. rettgeri - - + + - - - Prov. rustigia nii - +/- - + - - - +/- + - Prov. stuar tii
Typing methods • Phage typing • Bacteriocin typing (P/S typing) • PCR • The Dienes phenomenon

Pathogenesis • Strains of Pr. mirabilis are a prominent cause of Ø urinary tract infection. Ø Septicaemia. Ø infections, usually of surgical wounds or bedsores. Ø Otitis media. Ø May provoke the formation of calculi (stones) in the urinary tract.
Virulence factors • Urease. • Hemolysins. • Motility and swarming. • Flagella &Fimbriae. • Protease

Pathogenic mechanisms contd… • The enzyme hydrolyzes the urea in urine to ammonia and carbon dioxide. • This reaction may be important to the bacteria by providing them with a source of usable nitrogen for growth in urine. • However, the formation of ammonia also leads to alkalinization of the urine and at p. H values above 8, • calcium and magnesium ions are precipitated in the form of struvite (Mg. NHPO. 6 HO) and carbonate-apatite (Ca(PO)CO) 4421043 crystals. • Experiments in mice have confirmed that • Urease is a critical virulence determinant • for colonization of the urinary tract, • stone formation and • the development of acute pyelonephritis. •

11/4/2020 38
Laboratory diagnosis. • Specimens Midstream samples in UTI, Pus in pyogenic lesions • Collection : in a sterile container under aseptic conditions • Culture: BA , with 6% agar , MAc. Conkey

• Gram staining: Gram negative bacilli Noncapsulated & nonsporing • Hanging drop preparation • Biochemical reactions • PPA &Urease tests • Agglutination test • Antibiotic susceptibilty tests • Pr. mirabilis – UTI, Nosocomial - Indole (-) • Pr. vulgaris – less common - Indole (+) •

Wel Felix Reaction • Heterohilic agglutination • There are cross reaction between certain species of Proteus and Rickettsia (which cause typhus fever & it is grow only on Tissue culture). • � When treated pt serum of person infected with typhus fever with Proteus Ag from spp (OX 19, OXK and OX 2) will give +ve reaction. ‘X’ strains (non-motile Pr. Vulgaris) & Sera from typhus fever patients • Serologic diagnosis of rickettsial infections • OX 2, OX 19 and OXK strains used

Proteus bacilli • Cultures have putrefactive odour (fishy, seminal) • Swarming on solid agar Motile cells spread in successive waves → a thin filmy layer in concentric circles ↑ concentration of agar (6%) chloral hydrate, sodium azide, alcohol, sulphonamide inhibit swarming
Morganella morganii

• Morganella morganii, is a member of the tribe Proteeae (normal fecal flora that often causes infection in patients whose normal flora have been disturbed by antibiotic therapy) of the family Enterobacteriaceae, with two subspecies: M. morganii and M. sibonii. Morganella morganii has been regarded as a harmless opportunistic pathogen, however there are strains that carry "antibiotic-resistant plasmids" and have been associated with nosocomial outbreaks of infections.

Scientific classification Domain: Kingdom: Phylum: Bacteria Proteobacteria Class: Gammaproteobacteria Order: Family: Tribe: Genus: Species: Enterobacteriales Enterobacteriaceae Proteeae[1] Subspecies: Morganella Historical identification and systematics M. morganii M. m. sibonii Binomial name Morganella morganii Synonyms • Proteus morganii

Historical identification and systematics • Morganella morganii was first described by a British bacteriologist H. de R. Morgan in 1906 as Morgan's bacillus. Morgan isolated the bacteria from stools of infants who were noted to have had "summer diarrhea". Later in 1919 Winslow et al. , named Morgan's bacillus, Bacillus morganii. However in 1936, Rauss renamed B. morganii as Proteus morganii. Fulton in 1943, showed that B. columbensis and P. morganii were the same and defined the genus Morganella, due to the DNA-DNA hybridization. Genus Morganella has two species M. morganii and M. columbensis. However in 1962, a review article by Ewing reported that M. columbensis had been reidentified as Escherichia coli, therefore removing that organism from the genus Morganella.

DNA–DNA hybridisation • generally refers to a molecular biology technique that measures the degree of genetic similarity between pools of DNA sequences. It is usually used to determine the genetic distance between two species. When several species are compared that way, the similarity values allow the species to be arranged in a phylogenetic tree; it is therefore one possible approach to carrying out molecular systematics.

General characteristics • • facultative anaerobic oxidase-negative. appear off-white and opaque straight rods, about 0. 6 -0. 7 µm in diameter and 1. 0 -1. 7 µm in length. Motile by way of peritrichous flagella, but some strains do not form flagella at 30 °C. M. morganii is catalase-positive. indole test-positive Methyl red tests positive

Infections • Although a rare human pathogen, M. morganii has been reported as a cause of urinary tract infections, nosocomial surgical wound infections, peritonitis, CNS infection, endophthalmitis, pneumonia, chorioamnionitis, neonatal sepsis, pyomyositis, necrotizing fasciitis, and arthritis. • Patients in whom bacteremia develops are typically immunocompromised, diabetic, or elderly or have at least one serious underlying disease.

Role of bacteria • There have been several reports that M. morganii causes sepsis, ecthyma, endophthalmitis, chorioamnionitis, however more commonly urinary tract infections, soft tissue infections, septic arthritis, meningitis and bacteremia often with fatal consequences. • In a rare case published in 2003, a patient present with bilateral necrosis of both upper and lower eyelids. Upon microbial analysis the areas were shown to have heavy growth of M. morganii.
Morganella morganii • No swarming • Infrequent infections • UTI • Nosocomial wound infections

Kingdom: Phylum: Scientific classification Bacteria Proteobacteria Class: Gammaproteobacteria Order: Enterobacteriales Family: Enterobacteriaceae Genus: P. stuartii P. sneebia P. rettgeri P. rustigianii P. heimbachae P. burhodogranariea P. alcalifaciens Providencia Species

Providenci a • is a Gram negative, motile bacterium of the family Enterobacteriaceae. Some strains (P. stuartii, for example) are opportunistic pathogens in humans and can cause urinary tract infections, particularly in patients with long-term indwelling urinary catheters or extensive severe burns. Other strains (for example P. burhodogranariea and P. sneebia) are found in the haemolymph of Drosophila melanogaster fruit flies. • Some strains are sensitive to ampicillin.

Providencia species • Providencia rettgeri is pathogen of urinary tract and has caused nosocomial outbreaks • Providenicia stuartii can cause nosocomial outbreaks in burn units and has been isolated from urine • Both are phenylalanine deaminase positive

• The genus Providencia includes urease-producing gram-negative bacilli that are responsible for a wide range of human infections. Although most Providencia infections involve the urinary tract, they are also associated with gastroenteritis and bacteremia. Providencia infections are uncommon and are usually nosocomial. They represent an emerging problem because of the increasing prevalence of antibiotic resistance secondary to extended-spectrum beta-lactamase (ESBL).

• The 5 species currently in the genus Providencia, in descending order of prevalence, include • Providencia stuartii, • Providencia rettgeri, • Providencia alcalifaciens, • Providencia rustigianii, and • P heimbachae.

• The first species of the genus now known as Providencia was isolated by Rettger in 1904. The bacterium was initially seen in chickens in what was believed to be an epidemic of fowl cholera. The bacterium was not further characterized until 1918, when it was named Bacterium rettgerii by Hadley et al. Organisms belonging to the genus Providencia have undergone many taxonomic changes since their first description, with frequent confusion and overlap between organisms of the closely related genera Providencia, Proteus, and Morganella.
- Slides: 57